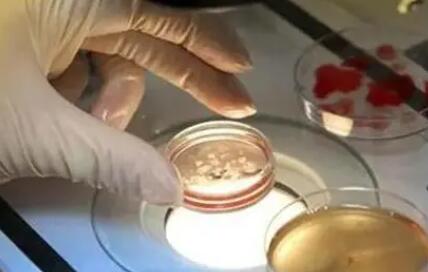
14dd4aef13e4622b7e9ad706616c5ff0.jpg

以下是东莞地区2025年三代试管婴儿的费用明细,以及一份避坑指南,帮助您更好地规划预算并避免不必要的开支。
东莞三代试管费用明细
| 费用项目 | 费用范围(人民币) | 备注 |
|---|---|---|
| 术前检查费 | 3000-8000 | 包括双方身体检查,评估生育能力 |
| 促排卵药物费 | 10000-30000 | 根据药物种类、剂量和疗程而定 |
| 手术及实验室操作费 | 40000-80000 | 包括取卵、胚胎培养、移植等 |
| 胚胎遗传学筛查费 | 10000-20000 | 如进行PGD/PGS等筛查 |
| 胚胎保存费 | 1000-3000/年 | 如有剩余胚胎需要冷冻保存 |
| 其他费用 | 500-5000 | 如住院押金、手术器械消毒费等 |
| 总费用 | 约75000-150000 | 根据个人情况有所不同 |
避坑指南
- 提前了解费用构成:在进行试管婴儿治疗前,务必向医院详细了解费用构成,包括各项检查、药物、手术及实验室操作的具体费用,避免后期出现不必要的争议。
- 选择正规医院:选择具有正规资质、设备先进、医生经验丰富的医院进行治疗,虽然费用可能相对较高,但成功率也更有保障。
- 咨询医生制定个性化方案:每个人的身体状况和生育需求都不同,因此建议咨询医生制定个性化的治疗方案,避免盲目跟风选择不必要的项目,增加费用负担。
- 注意药物选择:促排卵药物费用是试管婴儿治疗中的一项重要开支,建议根据自身情况选择合适的药物,避免盲目追求高端或进口药物,增加不必要的费用。
- 合理安排时间:试管婴儿治疗需要一定的时间周期,建议提前规划好时间,避免因为时间紧迫而选择加急服务或额外项目,增加费用。
- 保持理性消费:在治疗过程中,可能会遇到各种推销和服务升级的情况,建议保持理性消费,根据自身需求和经济状况做出选择。
综上所述,东莞地区2025年三代试管婴儿的费用因个人情况和所选医院等因素而异,但大致在7.5万元至15万元人民币之间。通过提前了解费用构成、选择正规医院、咨询医生制定个性化方案、注意药物选择、合理安排时间以及保持理性消费等方式,可以帮助您更好地规划预算并避免不必要的开支。







